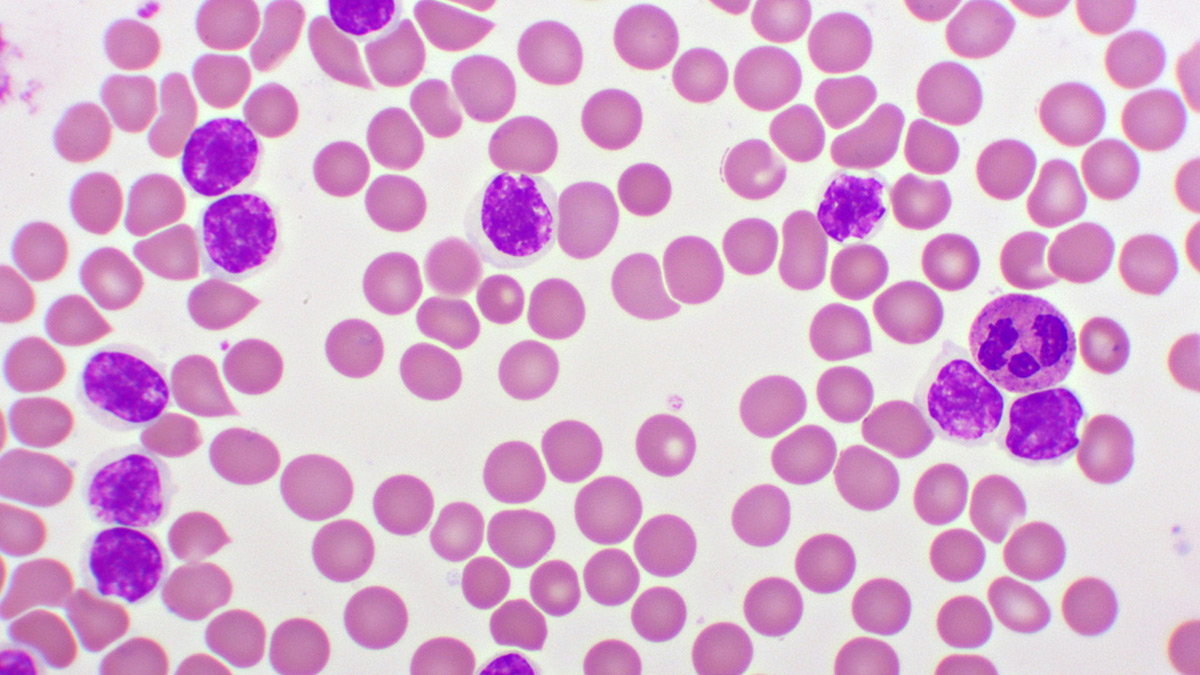
Lymphoma and CLL 2 - 2025-04-30T113448.024

Mike Peters, the voice of Welsh rock band The Alarm and a tireless cancer campaigner, passed away on April 29, 2025, after a three-decade fight against lymphoma and chronic lymphocytic leukaemia (CLL). Known for hits like Sixty Eight Guns and his work with U2 and Queen, Peters turned his diagnosis into a global mission for cancer awareness. Despite enduring multiple relapses and experimental treatments, he toured relentlessly, recorded music, and co-founded charities, proving that life with cancer could still burn brightly.
A Rockstar’s Fight Against Blood Cancer![mike peters death mn - 2025-04-30T113437.563]()
His battle began in 1995 with a lymphoma diagnosis, followed by chronic lymphocytic leukaemia (CLL) in 2005 and again in 2015. CLL, a slow-growing blood cancer, often causes fatigue, weight loss, and frequent infections. For Peters, it meant balancing chemotherapy, targeted therapies, and the uncertainty of remission while raising two sons and performing worldwide.
His wife Jules, who faced her cancer struggles, became his anchor. “We fought side by side,” Peters once said. “Cancer taught us to live fiercely”.
What Are Lymphoma and CLL?![Lymphoma and CLL 2 - 2025-04-30T113448.024]()
Dr Aditya Sarin, Associate Consultant, Medical Oncology, Sir Ganga Ram Hospital, Delhi, shares, "CLL damages white blood cells called lymphocytes, which weakens your body’s ability to fight infections over time. But many people live for years without feeling sick."
Key points:
- Who gets it? Mostly adults over 60, but younger people can too.
- Symptoms: Feeling tired all the time, swollen glands (neck/armpits), getting infections often, heavy sweating at night, and losing weight without trying.
- How it’s found: Usually through simple blood tests that show too many lymphocytes.
Below are short meanings of Lymphoma and CLL
- Lymphoma: Affects white blood cells, causing swollen lymph nodes and immune system damage.
- Chronic Lymphocytic Leukaemia (CLL): A blood/bone marrow cancer where abnormal cells crowd out healthy ones, leading to anaemia, infections, and fatigue.
Both cancers are treatable but incurable. Peters’ CLL required watchful waiting at first common approach for slow-growing cases-followed by targeted drugs like ibrutinib and chemo when symptoms worsened.
The Relentless Relapses![mike peters death reason cancer 3 - 2025-04-30T113441.288]()
His initial battle began in 1995 with a lymphoma diagnosis, followed by chronic lymphocytic leukaemia (CLL) in 2005. CLL, a slow-growing blood cancer, often causes fatigue, weight loss, and frequent infections. For Peters, it meant balancing chemotherapy, targeted therapies, and the uncertainty of remission, all while raising two sons and performing worldwide. In 2024, Peters faced Richter’s Syndrome, an aggressive lymphoma linked to CLL. Experimental treatments at Christie NHS Trust couldn’t halt the disease, yet he performed them weeks before his death. “I’m not afraid of dying,” he told fans. “I’m afraid of not living”.
His Cancer Relapse Timeline
- 2015: CLL returned, forcing Peters into another round of treatment.
- 2022: A quiet relapse prompted closer monitoring.
- April 2024: A lump appeared overnight in his neck. Biopsies revealed Richter’s Syndrome, an aggressive lymphoma linked to CLL. Doctors warned he had two months to live without urgent care.
Peters cancelled a 50-date U.S. tour days before departure, calling it “heartbreaking”. “I pleaded, ‘Can I just go for one week?’ But the cancer was moving too fast,” he said.
ALSO READ: Val Chmerkovskiy Shares His Experience, Passes Kidney Stone on A Plane: Is It Medically Possible?
Living and Rocking With Cancer
His story defied stereotypes. He headlined festivals mid-chemo, wrote albums about resilience (Blood Red), and urged fans. Mike Peters didn’t just survive cancer, he weaponised it. By sharing his journey, he gave patients hope and proved that even terminal diagnoses can’t silence a life well-lived. As he sang in Blaze of Glory: “We march on, hearts strong, carrying the flame”.
Also watch this video
How we keep this article up to date:
We work with experts and keep a close eye on the latest in health and wellness. Whenever there is a new research or helpful information, we update our articles with accurate and useful advice.
Current Version